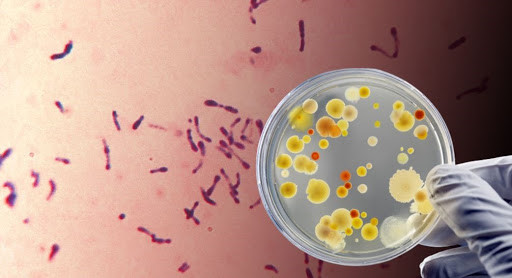
У Херсонській області зафіксовано спалах небезпечної хвороби

У Херсонській області зафіксовано спалах небезпечної хвороби
Українські медики виявили туляремію в подружньої пари з Херсонщини. В обох пацієнтів ще 7 серпня з’явилися виразки на шкірі кистей рук та підвищилася температура до 38,5°C, проте тільки через 6 днів вони звернулися за допомогою до лікарів. Про це на своєму Telegram-каналі повідомив Центр громадського здоров’я України.
«Під час лабораторних досліджень встановлено, що у біоматеріалах пацієнтів містяться фрагменти ДНК збудника туляремії Francisella tularensis. Встановлено, що хворий чоловік працює єгерем і під час одного з обходів мисливських угідь він знайшов у лісі напівмертвого зайця. Подружжя отримало травми рук, коли обробляло тварину вдома», – йдеться у повідомленні.
Зазначимо, що туляремія – гостра інфекційна хвороба, якою можуть заразитися люди та тварини. Вона передається контактним, аліментарним, аерогенним та трансмісивним шляхами. Ризик передачі туляремії від людини до людини мінімальний. Інкубаційний період може тривати до 30 днів. Без лікування хвороба ускладнюється й супроводжується лихоманкою, нагноєнням уражених лімфовузлів і розвитком артриту, менінгіту, енцефаліту, пневмонії та інфекційно-токсичним шоком.
До слова, в Одесі нещодавно виявили сибірську виразку.
Раніше «Судово-юридична газета» писала про нову форму пневмонії, яку зафіксували на Львівщині.
Підписуйтесь на наш Telegram-канал, щоб бути в курсі найважливіших подій.







































